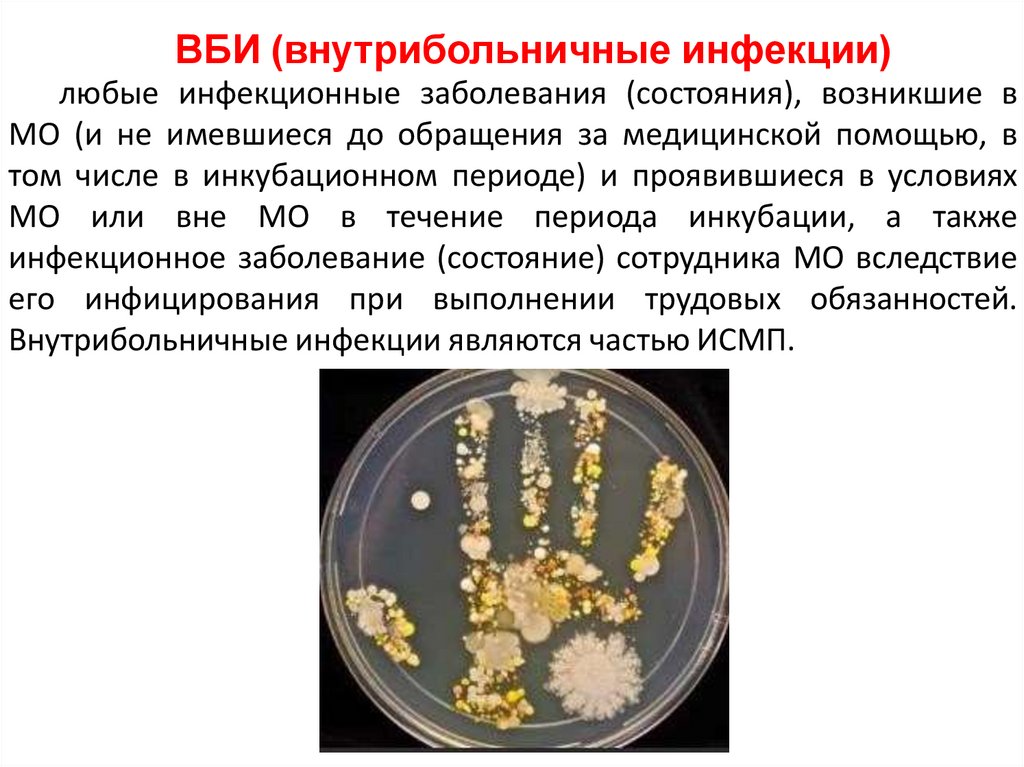

Похожие презентации:
Эпидемический процесс и инфекционный контроль в медицинской организации (профилактика ИСМП)
1.
ПМ.01 ПРОВЕДЕНИЕ МЕРОПРИЯТИЙ ПО ПРОФИЛАКТИКЕИНФЕКЦИЙ, СВЯЗАННЫХ С ОКАЗАНИЕМ МЕДИЦИНСКОЙ
ПОМОЩИ
МДК.01.01 Обеспечение эпидемиологической
безопасности персонала в медицинской организации
Лекция 1
Тема 1.1.
Эпидемический процесс и его звенья. Инфекции
и инфекционный процесс
2.
Цели лекцииИнфекционные болезни, понятия. Особенности
течения инфекционного процесса.
2.
Эпидемический процесс. Противоэпидемические
мероприятия. Мероприятия, направленные на
разрыв путей передачи возбудителя.
3.
Мероприятия, направленные на повышение
невосприимчивости населения к возбудителям.
4.
Роль медсестры в диагностике, лечении и
профилактике инфекционных заболеваний.
Устройство и режим инфекционных больниц.
1.
3.
План лекцииЗнакомство с аудиторией
Постановка целей и задач темы лекции
Изучение нового материала лекции
Обобщение полученной информации
(выводы)
Ответы на вопросы к лекции
Постановка домашнего задания
4.
Инфекция(позднелат. infectio заражение) — внедрение и
размножение микроорганизмов в макро-организме с
последующим развитием сложного комплекса их
взаимодействия — от носительства возбудителей до
выраженной болезни.
Возбудители инфекционных болезней
бактерии
спирохеты
низшие грибки
вирусы
простейшие
риккетсии
5.
Патогенность (болезнетворность)Непатогенные микроорганизмы, никогда не
вызывающие инфекционного процесса
Условно-патогенные – вызывают развитие
инфекционного процесса только при
определенных условиях.
Патогенные – возбудители, всегда вызывающие
развитие патогенного процесса
6.
БАКТЕРИИСтафилококки
Абсцесс, флегмоны,
пневмонии
Стрептококки
Ангина, бронхит, рожа,
пневмонии
Сальмонеллы
(2200 разновидностей)
Синегнойная
палочка
Энтеробактерии
Заболевания ЖКТ
7.
ВНУТРИКЛЕТОЧНЫЕ ПАРАЗИТЫВИЧ-инфекция
Гепатиты В и С
Энтеровирусы
(энтовирусная ангина, миалгия,
менингит)
Грипп, ОРВИ, Ковид
Герпес
8.
ГРИБЫАспергиллы (Aspergillus)
Заболевание - аспергиллез
Род Кандида (Candida)
ПРОСТЕЙШИЕ
Пневмоцисты (сегодня относят к грибам)
Кристоспоридии
9.
МНОГОКЛЕТОЧНЫЕ ОРГАНИЗМЫКлещ чесоточный
Вши
Гельминтозы
10.
Свойства микроорганизмов11.
Инфекционная безопасность –санитарно-противоэпидемических
комплекс
лечебно-профилактических,
организационных
мероприятий, направленных на уничтожение
микроорганизмов
на
эпидемиологически
значимых объектах медицинских организаций.
Инфекционный контроль –
это система организационных, профилактических и
противоэпидемических мероприятий, направленных
на
предупреждение
возникновения
и
распространения инфекционных заболеваний в МО
на основе результатов эпидемиологической
диагностики.
12.
Инфекционный процессСложный процесс взаимодействия возбудителя и
макроорганизма в определенных условиях
внешней и внутренней среды, включающий в
себя
патологические,
защитноприспособительные, компенсаторные реакции
Формы инфекционного процесса:
Острая;
Хроническая;
Латентная (скрыта);
Носительство.
13.
Цепочка передачи инфекцииИсточник
инфекции
Путь
передачи
Путь
передачи
Восприимчивый
организм
14.
«Входные» и «выходные» ворота инфекции15.
ИнвазивностьИнкубационный
период
Способность микроорганизма проникать в ткани и
органы макроорганизма и распространяться в них.
Промежуток времени от момента проникновения
возбудителя в макроорганизм до появления первых
клинических симптомов заболевания.
Вирулентные
микроорганизмы
Микроорганизмы, вызывающие заболевание.
Инфицирование
(внешней среды)
Присутствие патогенных микроорганизмов в
различных
субстанциях и на предметах внешней среды.
Носительство
(бациллоносительство)
Длительное существование патогенных или условнопатогенных микроорганизмов в тканях или органах
макроорганизма, не приводящие к развитию
инфекционного процесса.
Резистентность
Госпитальный штамм
микроорганизма
Устойчивость.
Микроорганизмы, изменившие свою структуру в ЛПУ
и
16.
Основные резервуары (источники) инфекции:Руки
1. энтеробактерии
2. серрация
3. синегнойная палочка
4. золотистый стафилококк
5. эпидермальный стафилококк
6. эшерихии
Носовая полость
1. Золотистый стафилококк
2. Эпидермальный стафилококк
17.
Основные резервуары (источники) инфекции:Глотка
1. стрептококк группы А
2. стрептококк группы В
3. энтеробактерии
4. синегнойная палочка
5. клебсиелла
Дыхательная система
1. легионелла
Половые органы:
1. стрептококки группы А
2. стрептококки группы В
18.
Основные резервуары (источники) инфекции:Мочевыделительная система
1. клебсиелла
2. энтеробактерии
3. серрация
4. синегнойная палочка
5. протей
Кишечник
1. стрептококк группы А
2. стрептококк группы В
3. синегнойная палочка
4. клебсиелла
19.
Основные резервуары микроорганизмов вмедицинской организации
Дыхательная аппаратура:
Жидкости для
Синегнойная палочка
внутривенного вливания:
энтеробактерии
20.
Основные резервуары микроорганизмов во внешнейсреде медицинской организации
Дезинфицирующие растворы пониженной
концентрации:
Синегнойная палочка
Резервуары для воды:
Burkholderia cepacia
граммотрицательные анаэробные палочки
Медицинское оборудование:
Burkholderia cepacia
Системы кондиционирования:
Легионелла
Загрязненные респираторы:
Атипичные микобактерии
21.
Основная характеристикавнутрибольничного микроорганизма
РЕЗИСТЕНТНОСТЬ
(устойчивость к антимикробным агентам)
Антибиотики
Антисептики
Дезинфицирующие средства
22.
ГЛАВНЫЙ ГОСУДАРСТВЕННЫЙ САНИТАРНЫЙ ВРАЧ РОССИЙСКОЙФЕДЕРАЦИИ
ПОСТАНОВЛЕНИЕ
от 28 января 2021 года N 4
Об утверждении санитарных правил и норм
СанПиН 3.3686-21
«Санитарно-эпидемиологические требования по
профилактике инфекционных болезней»
XLIV. Профилактика инфекций, связанных с
оказанием медицинской помощи
23.
Инфекции, связанные с оказаниеммедицинской помощи (ИСМП)
любое инфекционное заболевание, развившееся у
пациента в связи с оказанием ему любых видов
медицинской помощи (в медицинских организациях,
осуществляющих оказание медицинской помощи в
стационарных условиях, амбулаторно, в том числе на
дому, в условиях дневного стационара и вне медицинской
организации, в организациях социального обслуживания,
в организациях, осуществляющих образовательную
деятельность, санаторно-оздоровительных организациях
и других), а также случаи заражения инфекционными
болезнями медицинских работников в результате их
профессиональной деятельности.
24.
ВБИ (внутрибольничные инфекции)любые инфекционные заболевания (состояния), возникшие в
МО (и не имевшиеся до обращения за медицинской помощью, в
том числе в инкубационном периоде) и проявившиеся в условиях
МО или вне МО в течение периода инкубации, а также
инфекционное заболевание (состояние) сотрудника МО вследствие
его инфицирования при выполнении трудовых обязанностей.
Внутрибольничные инфекции являются частью ИСМП.
25.
Случаи инфекционных заболеваний, возникшие до поступленияв МО, проявившиеся или выявленные при поступлении
(после поступления в пределах инкубационного периода данной
нозологической формы), называются заносами инфекции и не
относятся к ИСМП. При заносе инфекционных заболеваний
необходимо проводить комплекс противоэпидемических
мероприятий согласно требованиям Санитарных правил к
профилактике отдельных инфекционных болезней.
26.
Возбудители ИСМПбактерии
грибы
риккетсии
простейшие
вирусы
прионы
эктопаразиты
Наиболее часто этиологическими агентами ИСМП являются условно-патогенные
микроорганизмы из группы ESCAPE: Enterococcus, Staphylococcus aureus, Acinetobacter
spp., Pseudomonas aeruginosa, Clostridium difficile, представители семейства
Enterobacteriaceae (Escherichia coli, Klebsiella pneumonia, Enterobacter spp., Proteus
spp.).
27.
Возникновение ИСМПЭкзогенное
инфицирование
Эндогенное
инфицирование
28.
Формы ИСМПГнойно-септические инфекции
новорожденных (ГСИ новорожденных):
бактериальный менингит, сепсис,
остеомиелит, омфалит, инфекции кровотока, пиодермия,
импетиго, панариций,
паронихий, мастит, неонатальная инфекция мочевых путей,
конъюнктивит и
дакриоцистит, пневмонии.
Гнойно-септические инфекции родильниц (ГСИ
родильниц): сепсис, инфекции соска и молочной
железы, связанные с деторождением, острый
перитонит, инфекция хирургической акушерской
раны, расхождение швов после кесарева сечения,
расхождение швов промежности, инфекции
мочевых путей после родов, инфекции органов
дыхания, осложняющие роды и послеродовой
период.
29.
Формы ИСМПИнфекции в области хирургического
вмешательства (ИОХВ)
Инфекции кровотока (ИК): инфекции,
связанные с инфузией, трансфузией и
лечебной инъекцией, иммунизацией.
Среди инфекций кровотока выделяют
катетер-ассоциированные инфекции
кровотока (КАИК)
Инфекции мочевыводящих путей
(ИМВП). Среди них выделяют
катетер-ассоциированные
инфекции мочевыводящих путей
30.
Формы ИСМПИнфеции нижних дыхательных путей
(ИНДП). Среди них выделяют ИВЛассоциированные ИНДП
Острые кишечные инфекции (ОКИ), в том
числе острые гепатиты A и E. Другие
сальмонеллезные инфекции
Воздушно-капельные инфекции
(ВКИ)
31.
Формы ИСМПТуберкулез впервые
выявленный,
активные формы.
Парентеральные инфекции:
ВИЧ, гепатиты B и C.
32.
Источники госпитальных инфекцийПАЦИЕНТЫ (основной источник)
Медицинский персонал
Лица, привлекаемые к уходу за
пациентом
Посетители, навещающие
пациентов
33.
Механизмы, пути (способы)передачи ИСМП
Путь передачи – совокупность механизмов и
факторов передачи, обеспечивающих
перемещение возбудителя во внешней среде
между источником и восприимчивым
организмом человека (хозяином).
Механизм передачи возбудителя инфекции –
это способ перемещения возбудителя из
зараженного организма в восприимчивый
организм «хозяина» инфекции.
34.
Механизм передачи возбудителя инфекцииВыведение
возбудителя
из
организма в
окружающу
ю среду
1
2
Пребывание
возбудителя в
окружающей
среде или
организме
живого
переносчика
Внедрение
возбудителя в
восприимчив
ый организм
3
35.
Механизмпередачи
ИСМП
Естественный
Искусственный
(артифициальный)
36.
Естественные пути передачиМеханизм
передачи
Пути передачи
• Контактный
передача
возбудителя при
попадании на кожу
или
слизистые
оболочки
(микротравмы)
Прямой – через
слизистые
оболочки и
кожные покровы
Непрямой – через
промежуточный
объект (посуда,
белье…)
Факторы
передачи
Кожные покровы
Слизистые
оболочки
Предметы обихода
37.
Механизм
передачи
• Аэрозольный
(аспирационный)
– вдыхание
возбудителя из
воздушной среды
Пути передачи
воздушно-капельный – капли из
дыхательных путей пациента
выбрасываются на расстояние 1
м и попадают на слизистые
хозяина.
Воздушно-пылевой –
возбудитель находится в мелких
каплях, которые образуются при
испарении крупных капель или
на частичках пыли (бытовая
пыль, частички кожи).
Факторы
передачи
Капли
секрета
дыхательных
путей
Частички
пыли
38.
Механизмпередачи
• Фекальнооральный –
проникновение
возбудителя из
кишечника
больного через
рот в организм
другого человека
Пути передачи
Водный
Пищевой
Факторы
передачи
Загрязненные
руки
Предметы
обихода
Вода
Продукты
питания
39.
Механизмпередачи
Пути передачи
• Вертикальный
Трансплацентарный
От матери к
плоду
через
плаценту
При
прохождении
родовых путей
Передача
возбудителя
насекомыми
Через
укусы
насекомых
• Трансмиссивный
Факторы
передачи
40.
Механизм передачиФактор передачи
• Транслокация - прохождение
жизнеспособных бактерий из
желудочно-кишечного тракта
через слизистую оболочку в
экстраинтестинальные участки
макроорганизма, например,
мезентериальные лимфоузлы
Желудочнокишечный тракт
(часто
транслоцируются
кишечная палочка,
протей,
энтеробактерии, из
транзиторных
штаммов - сенная
палочка)
41.
Искусственный путь передачиМеханизм
передачи
• Артифициальный
вариант
контактного
механизма
передачи, но
заражение
происходит вне
естественной
среды.
Пути передачи
Инструментальный
Гемотрансфузионный
Имплантационный
Парентеральный
Аппаратный
Факторы
передачи
Медицинские
инструменты
Препараты крови
Введение
контаминированных
растворов
Протезирование
(искусственный хрусталик,
кардиостимулятор)
Аппарат искусственной
вентиляции легких
42.
Возбудители ИСМППатогенные (шигеллы, стрептококки, mycobacterium tuberculosis,
вирусы гриппа, краснухи, кори, полиомиелита и др.; в большинстве
случаев вызывают заболевание при попадании в организм человека
вне зависимости от состояния его иммунитета).
Условно-патогенные (факультативные, облигатные;
стафилококки, протей, синегнойная палочка, уреаплазма,
анаэробные бактерии; вызывают септические и гнойнонекротические заболевания);
Оппортунистические (пневмоциста, возбудители вирусного
гепатита В и С, ВИЧ-инфекция) провоцируют развитие тяжёлого
инфекционного процесса на фоне существенного иммунодефицита
организма-хозяина; их патогенность способна проявляться в
условиях стационара даже при активном использовании лечебных и
диагностических вмешательств.
Основными возбудителями ИСМП являются условно-патогенные
организмы, на долю которых приходится до 80% всех инфекционных
вспышек в лечебных учреждениях.
43.
Факторы передачи ИСМПруки медперсонала (более 50%);
белье;
медицинское оборудование (аппараты ИВЛ,
гемодиализа,
эндоскопы
и
инструменты;
другие),
средства ухода за больными;
инъекционные растворы (в первую очередь в
многодозовых флаконах);
повторно
используемые
одноразовые
медицинские изделия;
воздух и другие.
44.
нарушения в организацииработы МО
причины,
способствующие
росту
заболеваемости
ИСМП
Нарушения санитарнотехнического состояния
Нарушения материального
обеспечения
Не соблюдение
противоэпидемического
режима
45.
Профилактические мероприятияпроводят исходя из положения, о том,
что каждый пациент расценивается
как потенциальный источник
гемоконтактных инфекций
(гепатиты B, C, ВИЧ-инфекция и
других).
46.
Осмотры медперсоналапредварительные
медицинские осмотры
(обследования) при
поступлении на работу
периодические
медицинские осмотры
Обязательному медицинскому освидетельствованию при поступлении на работу и
при периодических медицинских осмотрах (1 раз в год) с целью выявления ВИЧинфекции подлежат:
медицинские работники (врачи, средний и младший медицинский персонал) центров
по профилактике и борьбе со СПИДом, специализированных отделений и структурных
подразделений, занятых непосредственным обследованием, диагностикой, лечением,
обслуживанием, а также проведением судебно-медицинской экспертизы и другой
работы с лицами, инфицированными вирусом иммунодефицита человека, имеющие с
ними непосредственный контакт;
47.
Не допускаются к работемедицинские
с активными формамиработники:
туберкулеза. Решение о допуске к
профессиональной деятельности переболевших туберкулезом
принимает врачебная комиссия специализированной
фтизиатрической организации;
с лихорадкой, острыми воспалительными и гнойными
процессами или обострением хронических гнойновоспалительных заболеваний.
Профилактическая иммунизация персонала МО проводится в соответствии с
национальным и региональным календарями профилактических прививок, календарем
прививок по эпидемиологическим показаниям, а также в соответствии с
постановлениями главного государственного санитарного врача по субъекту Российской
Федерации.
48.
Главный государственныйсанитарный врач
Российской Федерации
Г.Г.Онищенко 6
ноября 2011 года
Национальная концепция
профилактики инфекций,
связанных с оказанием
медицинской помощи
49.
Наиболее уязвимые группы пациентовноворожденные дети,
пожилые люди,
пациенты с тяжелым течением основной
патологии и множественными
сопутствующими заболеваниями,
пациенты, подвергающиеся агрессивным и
инвазивным медицинским манипуляциям,
трансплантации органов и т.п.
50.
Причины возникновения ИСМПНедостаточная материально-техническая
база МО
Недостаток стерилизованного оборудования
Дефицит моющих и дезинфицирующих
средств
Несоблюдение правил асептики и
антисептики, дезинфекции и стерилизации
Лекарственная устойчивость возбудителя
Несоблюдение гигиены рук
Несвоевременная изоляция больных и
51.
52.
Пути профилактики ИСМПУстранить
Защитить
Прервать
Источник
инфекции
Механизм и
факторы
передачи
инфекции
Восприимчивый
организм
53.
Медицинский персонал обязан:соблюдать правила личной гигиены: принимать душ или
ванну, содержать в чистоте волосы и ногти, стирать личную
одежду, защищать дыхательные пути при чихании и кашле
других людей;
соблюдать уровни мытья рук, правила пользования
сменной одеждой, надевания и снимания защитных средств
надевать медицинские перчатки соответствующего
размера при контакте с кровью и другими биологическими
жидкостями, а также потенциально инфицированным
материалом.
54.
Домашнее заданиеПрофессиональный уход за пациентом. Младшая медицинская сестра :
учебник / С. И. Двойников, С. Р. Бабаян, Ю. А. Тарасова [и др. ] ; под ред. С.
И. Двойникова, С. Р. Бабаяна. - Москва : ГЭОТАР-Медиа, 2023. - 592 с. - ISBN
978-5-9704-7303-0. - Текст : электронный // ЭБС "Консультант студента" :
[сайт]. - URL : https://www.studentlibrary.ru/book/ISBN9785970473030.html. Режим доступа : по подписке. Раздел 3. Безопасная среда.
Сметанин, В. Н. Профилактика инфекций, связанных с оказанием
медицинской помощи / В. Н. Сметанин. - Москва : ГЭОТАР-Медиа, 2022. 480 с. - ISBN 978-5-9704-6419-9. - Текст : электронный // ЭБС "Консультант
студента" : [сайт]. - URL :
https://www.studentlibrary.ru/book/ISBN9785970464199.html. - Режим
доступа : по подписке.
Раздел 2. Понятие об инфекции и инфекционном процессе.
Раздел 3. Эпидемический процесс.

Медицина
Медицина








